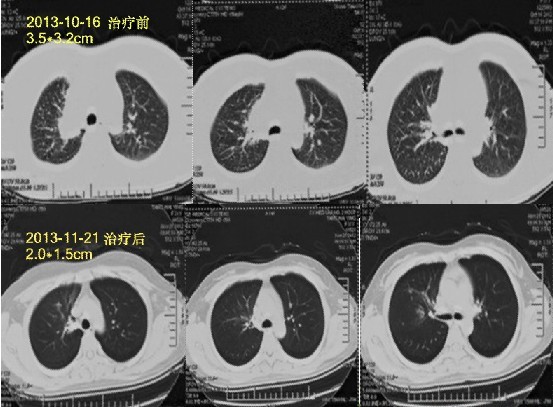
肺癌Ⅳ期：全身热疗+P53基因治疗2疗程健康出院

67411人觉得很有用

67086人觉得很有用

35459人觉得很有用

8158人觉得很有用

5116人觉得很有用

76804人觉得很有用

70401人觉得很有用

40655人觉得很有用

12225人觉得很有用

89734人觉得很有用
电话咨询:020-81116661/020-81116660 专家QQ:1793384282 地址:广州市白云区金沙洲礼传东街1号(地铁6号线横沙站下车)
Copyright © 2016 广州中医药大学金沙洲医院 版权所有 备案号:粤ICP备15031204号-1
注:本网站信息仅供参考,不能作为诊疗及医疗依据,未经授权请勿复制及转载.
![]()

![]()